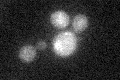
YNL262W
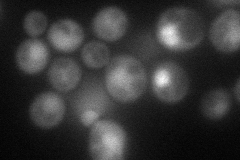
YNL262W

View description
Catalytic subunit of DNA polymerase (II) epsilon, a chromosomal DNA replication polymerase that exhibits processivity and proofreading exonuclease activity; also involved in DNA synthesis during DNA repair; interacts extensively with Mrc1p
Localization:
Intensity:
Fold change:
Significance:
-
C’ GFP library in SD
below threshold14.99 -
N' NOP1pr-GFP in SD
cytosol,nucleus64.451 -
N' TEF2pr-mCherry in SD

nucleus56.147 -
N' NATIVEpr-GFP in SD

below threshold18.7547 -
N' TEF2pr-VC and Cyto-VN in SD

cytosol,nucleus31.8897 -
C’ GFP library in SD+DTT

cytosol14.140.94No -
C’ GFP library in SD+H2O2

cytosol19.331.28No -
C’ GFP library in Starvation Media

cytosol17.081.13No -
C’ GFP library on the background of Pup2-DaMP

below threshold -
C’ GFP library on the background of CCT mutant

below threshold16.49871.09971No
